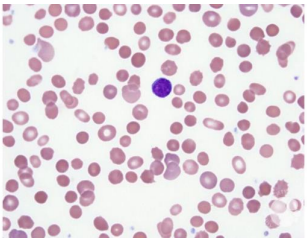
Enunciado 4305611-1

Internet: https://imagebank.hematology.org/atlas/60308
Uma criança de 6 anos de idade é levada para avaliação por apresentar fadiga, palidez e icterícia leve. Os pais notaram que, nas últimas semanas, a criança está mais cansada, com episódios de tontura. O exame laboratorial revela hemoglobina de 8 g/dL, bilirrubina indireta aumentada, reticulocitose. Foi realizado esfregaço de sangue periférico (conforme imagem).
A respeito do quadro clínico e laboratorial, assinale a alternativa que apresenta a hipótese mais provável, bem como manejo.